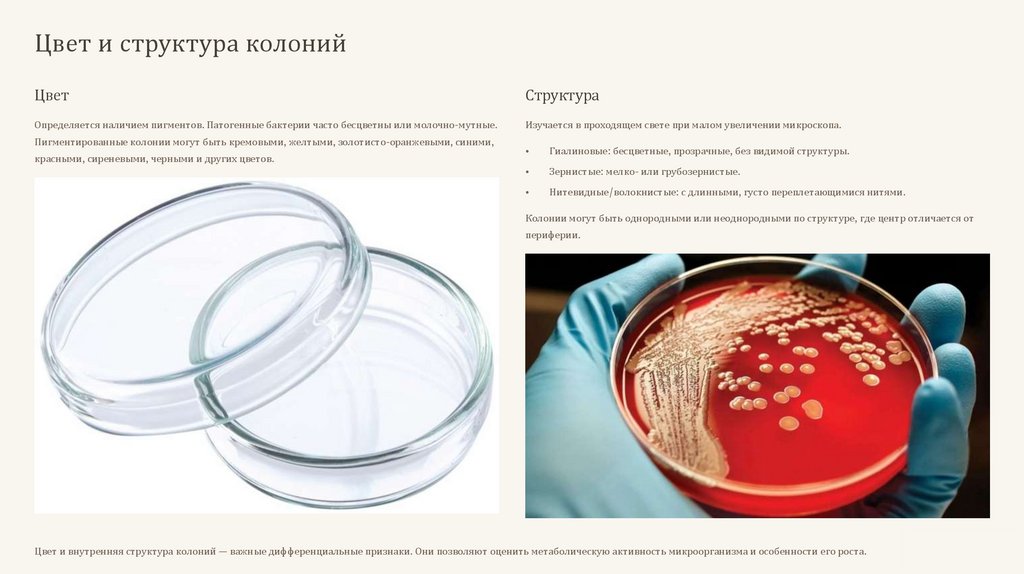

Similar presentations:
микробиология
1.
Характеристика ростамикроорганизмов
2.
Морфология колоний на плотных средах: РазмерТочечные
Диаметр < 1 мм
Мелкие
Диаметр 1-2 мм
Средние
Диаметр 2-4 мм
Крупные
Диаметр 4-6 мм и более
Размер колоний — один из первых признаков, определяемых при макроскопическом изучении. Он варьируется от точечных
образований до крупных, различимых невооруженным глазом структур. Этот параметр важен для предварительной классификации
и выделения чистых культур.
3.
Форма и контур края колоний4.
Рельеф и поверхность колоний1
2
Рельеф
Поверхность
Определяется приподнятостью над средой и вертикальным
Изучается лупой или микроскопом. Различают матовую/блестящую,
контуром. Бывает каплеобразный, куполообразный,
сухую/влажную, гладкую (S-формы) или шероховатую (R-формы). S-
плосковыпуклый, конусообразный, с приподнятой серединой, с
формы образуются при плотном контакте клеток, R-формы — при
вдавленным центром, плоский.
сохранении цитоплазматических мостиков, что создает цепочки.
Рельеф и текстура поверхности колоний обусловлены особенностями клеточного деления и упаковки клеток. Эти признаки важны для глубокого
понимания биологии микроорганизмов и их видовой идентификации.
5.
Цвет и структура колонийЦвет
Структура
Определяется наличием пигментов. Патогенные бактерии часто бесцветны или молочно-мутные.
Изучается в проходящем свете при малом увеличении микроскопа.
Пигментированные колонии могут быть кремовыми, желтыми, золотисто-оранжевыми, синими,
красными, сиреневыми, черными и других цветов.
Гиалиновые: бесцветные, прозрачные, без видимой структуры.
Зернистые: мелко- или грубозернистые.
Нитевидные/волокнистые: с длинными, густо переплетающимися нитями.
Колонии могут быть однородными или неоднородными по структуре, где центр отличается от
периферии.
Цвет и внутренняя структура колоний — важные дифференциальные признаки. Они позволяют оценить метаболическую активность микроорганизма и особенности его роста.
6.
Консистенция колонийКонсистенция колонии определяется путем механического взаимодействия с ней
бактериологической петлей. Этот показатель характеризует физическое состояние
колонии и ее адгезионные свойства.
Пастообразные
Легко снимаются и размываются, как сливочное масло.
Вязкие/Слизистые
Прилипают к петле и тянутся за ней, указывая на образование капсулы или
внеклеточного матрикса.
Волокнистые/Кожистые
Плотные, снимаются целиком в виде пленки, характерны для микроорганизмов,
образующих прочные биопленки.
Хрупкие/Сухие
Рассыпаются при прикосновении петли, что часто связано с особенностями
клеточной стенки.
7.
Особенности роста на жидких средахРост микроорганизмов в жидких питательных средах менее разнообразен, чем на плотных, но также имеет
характерные формы, важные для идентификации и понимания физиологии бактерий.
Равномерное помутнение
Вся среда мутнеет, цвет может меняться из-за пигмента. Характерно для факультативных анаэробов,
равномерно распределяющихся в толще среды.
Придонный рост
Образование осадка на дне пробирки, который может быть скудным или обильным, крошковидным,
гомогенным, волокнистым или в виде хлопьев. Характерен для анаэробных бактерий.
Пристеночный рост
Бактерии растут, прикрепляясь к стенкам сосуда, образуя хлопья или зерна, при этом среда остается
прозрачной. Указывает на адгезивные свойства микроорганизмов.
Поверхностный рост (пленка)
Формирование пленки на поверхности: тонкой, влажной, плотной, сухой, сморщенной. Характерен для
аэрофилов, активно использующих атмосферный кислород.
8.
Рост на полужидких средах ибиохимические свойства
Рост на полужидких средах
Используется для определения подвижности. Подвижные микробы вызывают
равномерное помутнение по всей толще агара. Неподвижные растут только по
ходу прокола, образуя "сосульки".
Отношение к кислороду
Посевом уколом в столбик агара определяют: облигатные аэробы (верх),
анаэробы (низ), факультативные анаэробы (равномерно), микроаэрофилы (в
узкой зоне под поверхностью).
Биохимические свойства микробов — это ключевые характеристики для их точной
идентификации. Они отражают метаболические пути, наличие специфических
ферментов и реакцию на условия окружающей среды.
9.
Ферментативная активность: Углеводы и белкиИспользование углеводов (Ряд Гисса)
Протеолитическая активность
Определяется посевом суспензии клеток в среды с различными углеводами и
индикатором. Изменение цвета индикатора указывает на расщепление углевода с
образованием кислоты. Наличие поплавков позволяет регистрировать образование газа.
Способность микроорганизмов разжижать желатину или пептонизировать молоко.
Разжижение желатины: культуру уколом засевают в желатину. Отмечают скорость и
характер разжижения (послойное, воронкообразное, пузырчатое).
Короткий ряд: глюкоза, лактоза, сахароза, мальтоза, маннит.
Каталазная активность: нанесение 10% перекиси водорода на колонию. Выделение
Длинный ряд: дополнительно арабиноза, ксилоза, рамноза, галактоза, полисахариды, спирты. пузырьков газа указывает на наличие каталазы.
Характер роста в молоке: оценивают изменение цвета индикатора (образование
Результаты учитывают через 2-10 суток.
кислоты), формирование сгустка, пептонизацию казеина.
10.
Образование конечных продуктовметаболизма
Индол
Образуется при расщеплении триптофана. Метод Мореля: полоска фильтровальной
бумаги с щавелевой кислотой окрашивается в розовый цвет в присутствии индола.
Аммиак
Продукт аммонификации белков. Лакмусовая бумажка, закрепленная над средой,
меняет цвет с красного на синий при выделении аммиака.
Сероводород
Образуется при расщеплении серосодержащих аминокислот. Полоска фильтровальной
бумаги, пропитанная ацетатом свинца, чернеет в присутствии сероводорода.
Выявление специфических конечных продуктов метаболизма является важным диагностическим
критерием, дополняющим морфологические и ферментативные тесты. Эти биохимические
реакции позволяют более точно идентифицировать микроорганизмы.

biology
biology








